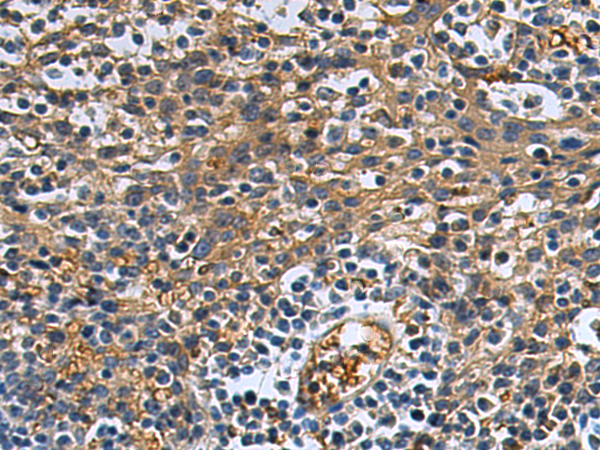
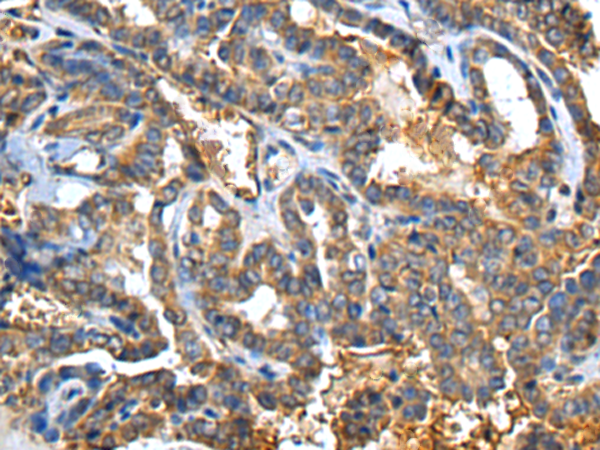

-
分类: 科研抗体货号: P01395别名: GK1; GALK; HEL-S-19应用: WB,IHC反应种属: Human, Mouse
-
分类: 科研抗体货号: P01330别名: EL; EDL; PRO719应用: IHC反应种属: Human
-
分类: 科研抗体货号: P01408别名: GLIPR; RTVP1; CRISP7应用: WB,IHC反应种属: Human, Mouse
-
分类: 科研抗体货号: P01392别名: RP11-68I18.1应用: WB,IHC反应种属: Human, Mouse
-
分类: 科研抗体货号: P01389别名: ALKBH9应用: WB,IHC反应种属: Human
-
分类: 科研抗体货号: P01453别名: DHRS10; SDR47C1; retSDR3应用: WB,IHC反应种属: Human, Mouse
-
分类: 科研抗体货号: P01385别名: FMNL; FHOD4; KW-13; C17orf1; C17orf1B应用: WB,IHC反应种属: Human, Mouse
-
分类: 科研抗体货号: P01451别名: HSD17; SDR9C2; EDH17B2应用: WB,IHC反应种属: Human
-
分类: 科研抗体货号: P01381别名: TTC11; CGI-135应用: WB,IHC反应种属: Human, Mouse, Rat
-
分类: 科研抗体货号: P01447别名: HDL; 11-DH; HSD11; HSD11B; HSD11L; CORTRD2; SDR26C1; 11-beta-HSD1应用: IHC反应种属: Human

鄂公网安备42018502007531号
鄂公网安备42018502007531号

